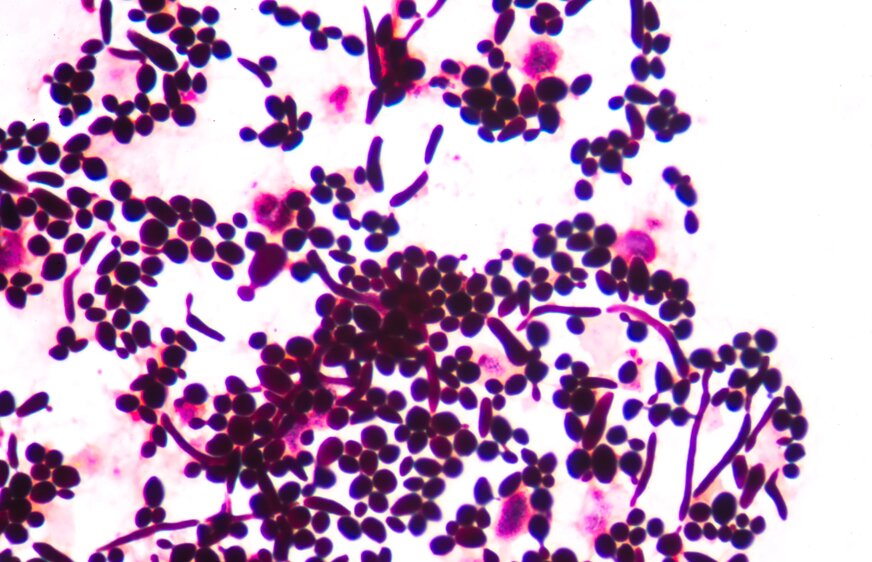
Image

Nový liek zastavuje starnutie na bunkovej úrovni: Je toto kľúč k večnej mladosti?
Vedci z Queen Mary University of London ohlásili prelomový objav v boji proti starnutiu. Vyvinuli novú triedu lieku s názvom Rapalink-1, ktorý dokáže spomaliť proces starnutia priamo na bunkovej úrovni. Tento liek bol vyvinutý na základe už existujúceho imunosupresíva rapamycínu, o ktorom je známe, že predlžuje život buniek a laboratórnych hlodavcov.
V rámci experimentov vedci použili kvasinky (Schizosaccharomyces pombe) a zistili, že Rapalink-1 predĺžil ich životnosť v podobnej miere ako rapamycín. Tento sľubný výskum bol publikovaný v odbornom časopise Communications Biology.

Zdroj Foto: Kumar et al., Commun. Biol., 2025
Kľúčom k úspechu je spôsob, akým liek ovplyvňuje jednu zo základných biologických dráh v našom tele. Rapalink-1 pôsobí na biologickú dráhu známu ako TOR (Target of Rapamycin), ktorá je úzko spojená so starnutím buniek a chorobami a je takmer identická u kvasiniek aj u ľudí. Konkrétne „brzdí“ aktivitu jej časti nazývanej TORC1, ktorá je zodpovedná za rast buniek.
Výsledkom je, že bunky rastú pomalšie, ale žijú podstatne dlhšie. Mechanizmus tohto lieku odhaľuje fundamentálny kompromis v biológii: energia, ktorú bunka využíva na rýchly rast a delenie, je v nepriamom vzťahu s energiou potrebnou na dlhodobú údržbu a prežitie.
Rapalink-1 v podstate oklame bunku, aby uprednostnila prežitie pred rastom. Tento princíp je známy aj z výskumov kalorickej reštrikcie, kde znížený príjem kalórií takisto vedie k predĺženiu života. Liek teda nevytvára nový biologický stav, ale chemicky manipuluje s existujúcim prepínačom v bunke, čím ju núti prejsť do režimu dlhodobej údržby.
Ešte fascinujúcejšie je prepojenie tohto procesu s našou stravou a mikroorganizmami v našich črevách. Molekulárna analýza ukázala, že Rapalink-1 zvyšuje produkciu enzýmov, ktoré premieňajú látku zvanú agmatín. Agmatín je zlúčenina, ktorú produkujú baktérie v našom tráviacom trakte a prijímame ju aj v strave, a jeho premena nepriamo ovplyvňuje gény spojené so starnutím.
Vedci však varujú pred unáhleným užívaním agmatínových doplnkov, pretože ich účinky sú komplexné a nie vždy prospešné. Tento objav zásadne mení pohľad na starnutie. Už to nie je len jednoduchý proces opotrebovania, ale komplexný systémový problém, ktorý zahŕňa genetiku (dráha TOR), farmakológiu (liek) a mikrobióm (produkcia agmatínu).
Naznačuje to, že budúce terapie proti starnutiu nebudú spočívať v jedinej „zázračnej“ tabletke. Pravdepodobne pôjde o holistický prístup kombinujúci cielené lieky so zmenami v stravovaní a intervenciami zameranými na podporu zdravého črevného mikrobiómu.
Zdroj: sciencealert.com.
Zdroj Foto: depositphotos.com.
Zobrazit Galériu







